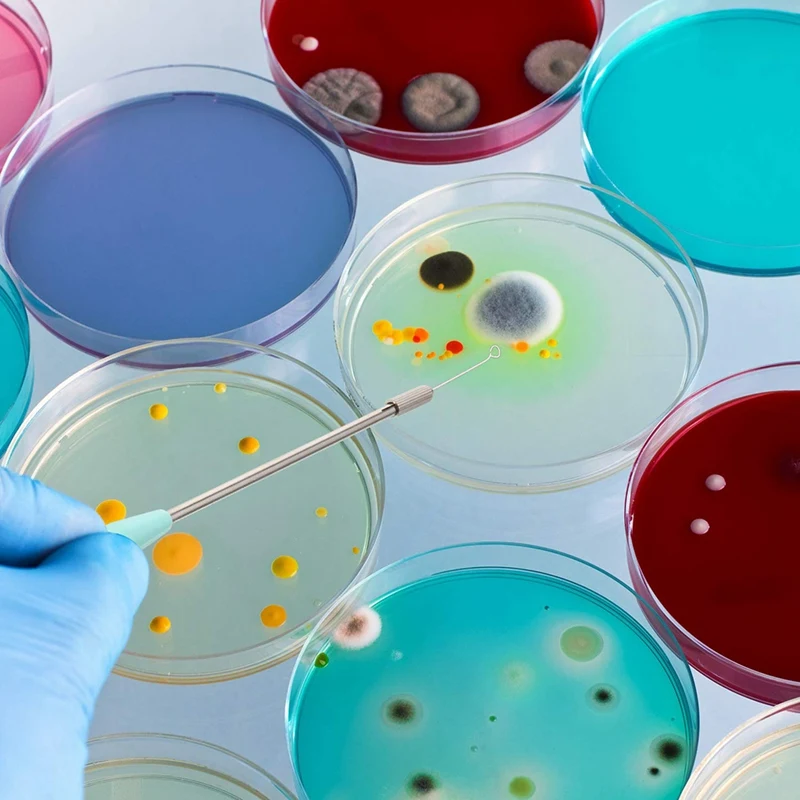
thumb

2 Pieces Reusable Inoculating Loop With 90 Replaceable Nichrome Needle Tip Inoculation Rings Inoculation Rod For Lab

sku: 1005004139100145
ACCORDING TO OUR RECORDS THIS PRODUCT IS NOT AVAILABLE NOW
$9.29
Shipping from: China
Price history chart & currency exchange rate
Customers also viewed

$9.16
y2k IA Magic Fairy футболка kawaii Original Graphic ropa de mujer мужская женская одежда Минималистичный Мужской Женский Kpop Нейтральный Повседневный
aliexpress.ru
$21.73
Genuine Leather Women Handbag Solid High Quality Cow Leather Female Crossbody Shoulder Bag Small Messenger Bags for Women
aliexpress.com
$167.65
Pure Sine Wave Inverter 12V 24V 48V DC to AC 220V 230V Voltage Converter 12000W Solar Power Bank Off Grid For Home Transformer
aliexpress.com
$1.83
50M/Roll Nylon Cords Thread Chinese Knot Macrame Cord Bracelet Braided String DIY Tassels Beading Jewelry Making String Thread
aliexpress.com
$16.19
Women Vintage Solid Knee-length Sundress ZANZEA Summer Lapel Neck Short Sleeve Shirt Dress Robe Femme Casual Loose Work Vestido
aliexpress.com
$18.26
6.5" LCD For Xiaomi Redmi 10 Prime 21061119BI LCD Display Touch Panel Screen Digitizer with Frame Assembly
aliexpress.com
$21.27
Kidstoy Parking Lot Storage Display Box 130Pcs Building Blocks for City Speed Champion Racing Car Bricks Toys Children Gift
aliexpress.com
$16.80
951-12771A Carburetor for MTD 951-12771 751-12771 751-12771A 751-12823 Craftsman Huskee Troy-Bilt Yard-Man carb
aliexpress.com
$72.00
Elegant Pointed Toe Plaid Evening Shoes Italian Zipper Increase Height Short Boots Social Man Genuine Leather Party Boots
aliexpress.com
$12.00
USB Charging Dock Port Socket Jack Connector Charge Board Flex Cable For Xiaomi Mi 9 Pro 9SE
aliexpress.com
$1,800.00
Excavator Parts 960F Wheel Loader C7.1 Engine Controller Computer Board 462-0007 462-0006
aliexpress.com
$5.75
Chef Waiter Cafe Shop Waiter Pure Color Cooking Kitchen Apron for Woman Men BBQ Hairdresser Aprons Bibs Kitchen Accessory
aliexpress.com
$4.45
Cleaning Oversleeves Reusable Arm Sleeves Cleaning Oversleeve Oilproof Oversleeves Sleeve Protectors Reusable Oversleeves
aliexpress.com
$8.29
New Gf07 Mini Enhanced Magnetic Positioner Car Gps Locator Anti-Lost Record Tracking Device Magnet Adsorption Function Portable
aliexpress.com
$1,230.00
New Display For Original BMW F900R F750GS F850GS R1200GS S1000R Speedometer Lcdscreen Instrument LCD Screen
aliexpress.com
$14.85
LastDan AC Charger Adapter Compatible With OTC Genisys Touch PC VCI Power Supply Pegisys 3825 M-VCI
walmart.com
$500.49
Portable Grille Gril Barbacoa Portatil Barbeque Fire Pit Churrasco Barbecue for Outdoor Churrasqueira Electric Bbq Grill
aliexpress.com
$2.99
Summer Clothes 2022 Love You Cat Printed T-Shirt Baby Things For Girls Clothes For Boys T Shirt Kids Boy White Short Sleeve Tops
aliexpress.com
$18.08
Short Sleeve Print T-shirt Women Casual Summer T Shirt Girl Sexy 2021 Tee Tshirt V-neck Loose Top T-shirt Streetwear
aliexpress.com
$4.78
Hot Sale Retro Linen Cartoon pattern Digital Printings Cushion Cover Case Polyester Throw Pillows Cushions For Home Decor
aliexpress.com
$2.98
Women Graphic Nail Theme Fashion Short Sleeve Spring Summer Cartoon Print Female Clothes Tops Tees Tshirt T-Shirt
aliexpress.com
$14.06
Hot Sale Room Wall Mounted Air Conditioning Cleaning Bag Split Air Conditioner Washing Cover Waterproof Anti-Dust Protector for
aliexpress.com
$5.00
Legosi Beastars Crew Socks Ladies Comfortable Winter Funny Women Black Breathable Autumn Cartoon Best Pattern Sports Unisex
aliexpress.com
$34.40
Большие часы, настенные часы с механизмом для гостиной, черные креативные бесшумные часы с виниловой пластиной, стеклянные кухонные часы, д...
aliexpress.com
$24.24
Applicable Huami Amazfit A res Mi-moving Smart Watch Battery 402120 Polymer Lithium Cod 3.8V
aliexpress.com
$11.08
Сумка для велосипеда переднюю верхнюю раму велосипедная сумка Водонепроницаемый чехол для телефона с сенсорным экраном MTB пакет аксессуар...
aliexpress.com
$18.79
Fashion O-neck Knitted Jumpers for Women Leopard Patchwork Sweater Women Loose Autumn Winter Sweater Female Pullovers Tops 2021
aliexpress.com
$21.00
Men's Hoodie Can_t hear you i_m gamingCotton Vintage Cute Top quality Hip-Hop Sweat Capuche 36928
aliexpress.com
$17.43
Men's Watch Casual Fashion Quartz Watch Luminous Waterproof Steel Belt Business Dual Calendar Watch
aliexpress.com
$2.94
Кожаный Чехол Для Телефона С Застежкой Для Samsung Galaxy A20S - Черный, Galaxy A20s
tvc-mall.com
$2.40
Charging Flex Cable With Microphone For XiaoMi Mi 6 Mix 2S Max 3 2 6X 5X Mic Charger Port Dock Connector
aliexpress.com














